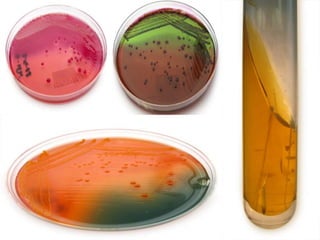

Escherichia coli is a common bacteria found in the intestines of humans and animals. While most E. coli strains are harmless, some can cause illness. There are several pathogenic types of E. coli including enterohemorrhagic E. coli (EHEC), enterotoxigenic E. coli (ETEC), enteroinvasive E. coli (EIEC), and enteropathogenic E. coli (EPEC). These pathogenic strains cause illnesses ranging from mild diarrhea to bloody diarrhea and even life-threatening complications like hemolytic uremic syndrome. Pathogenic E. coli are identified through tests of their genetic and phenotypic characteristics.